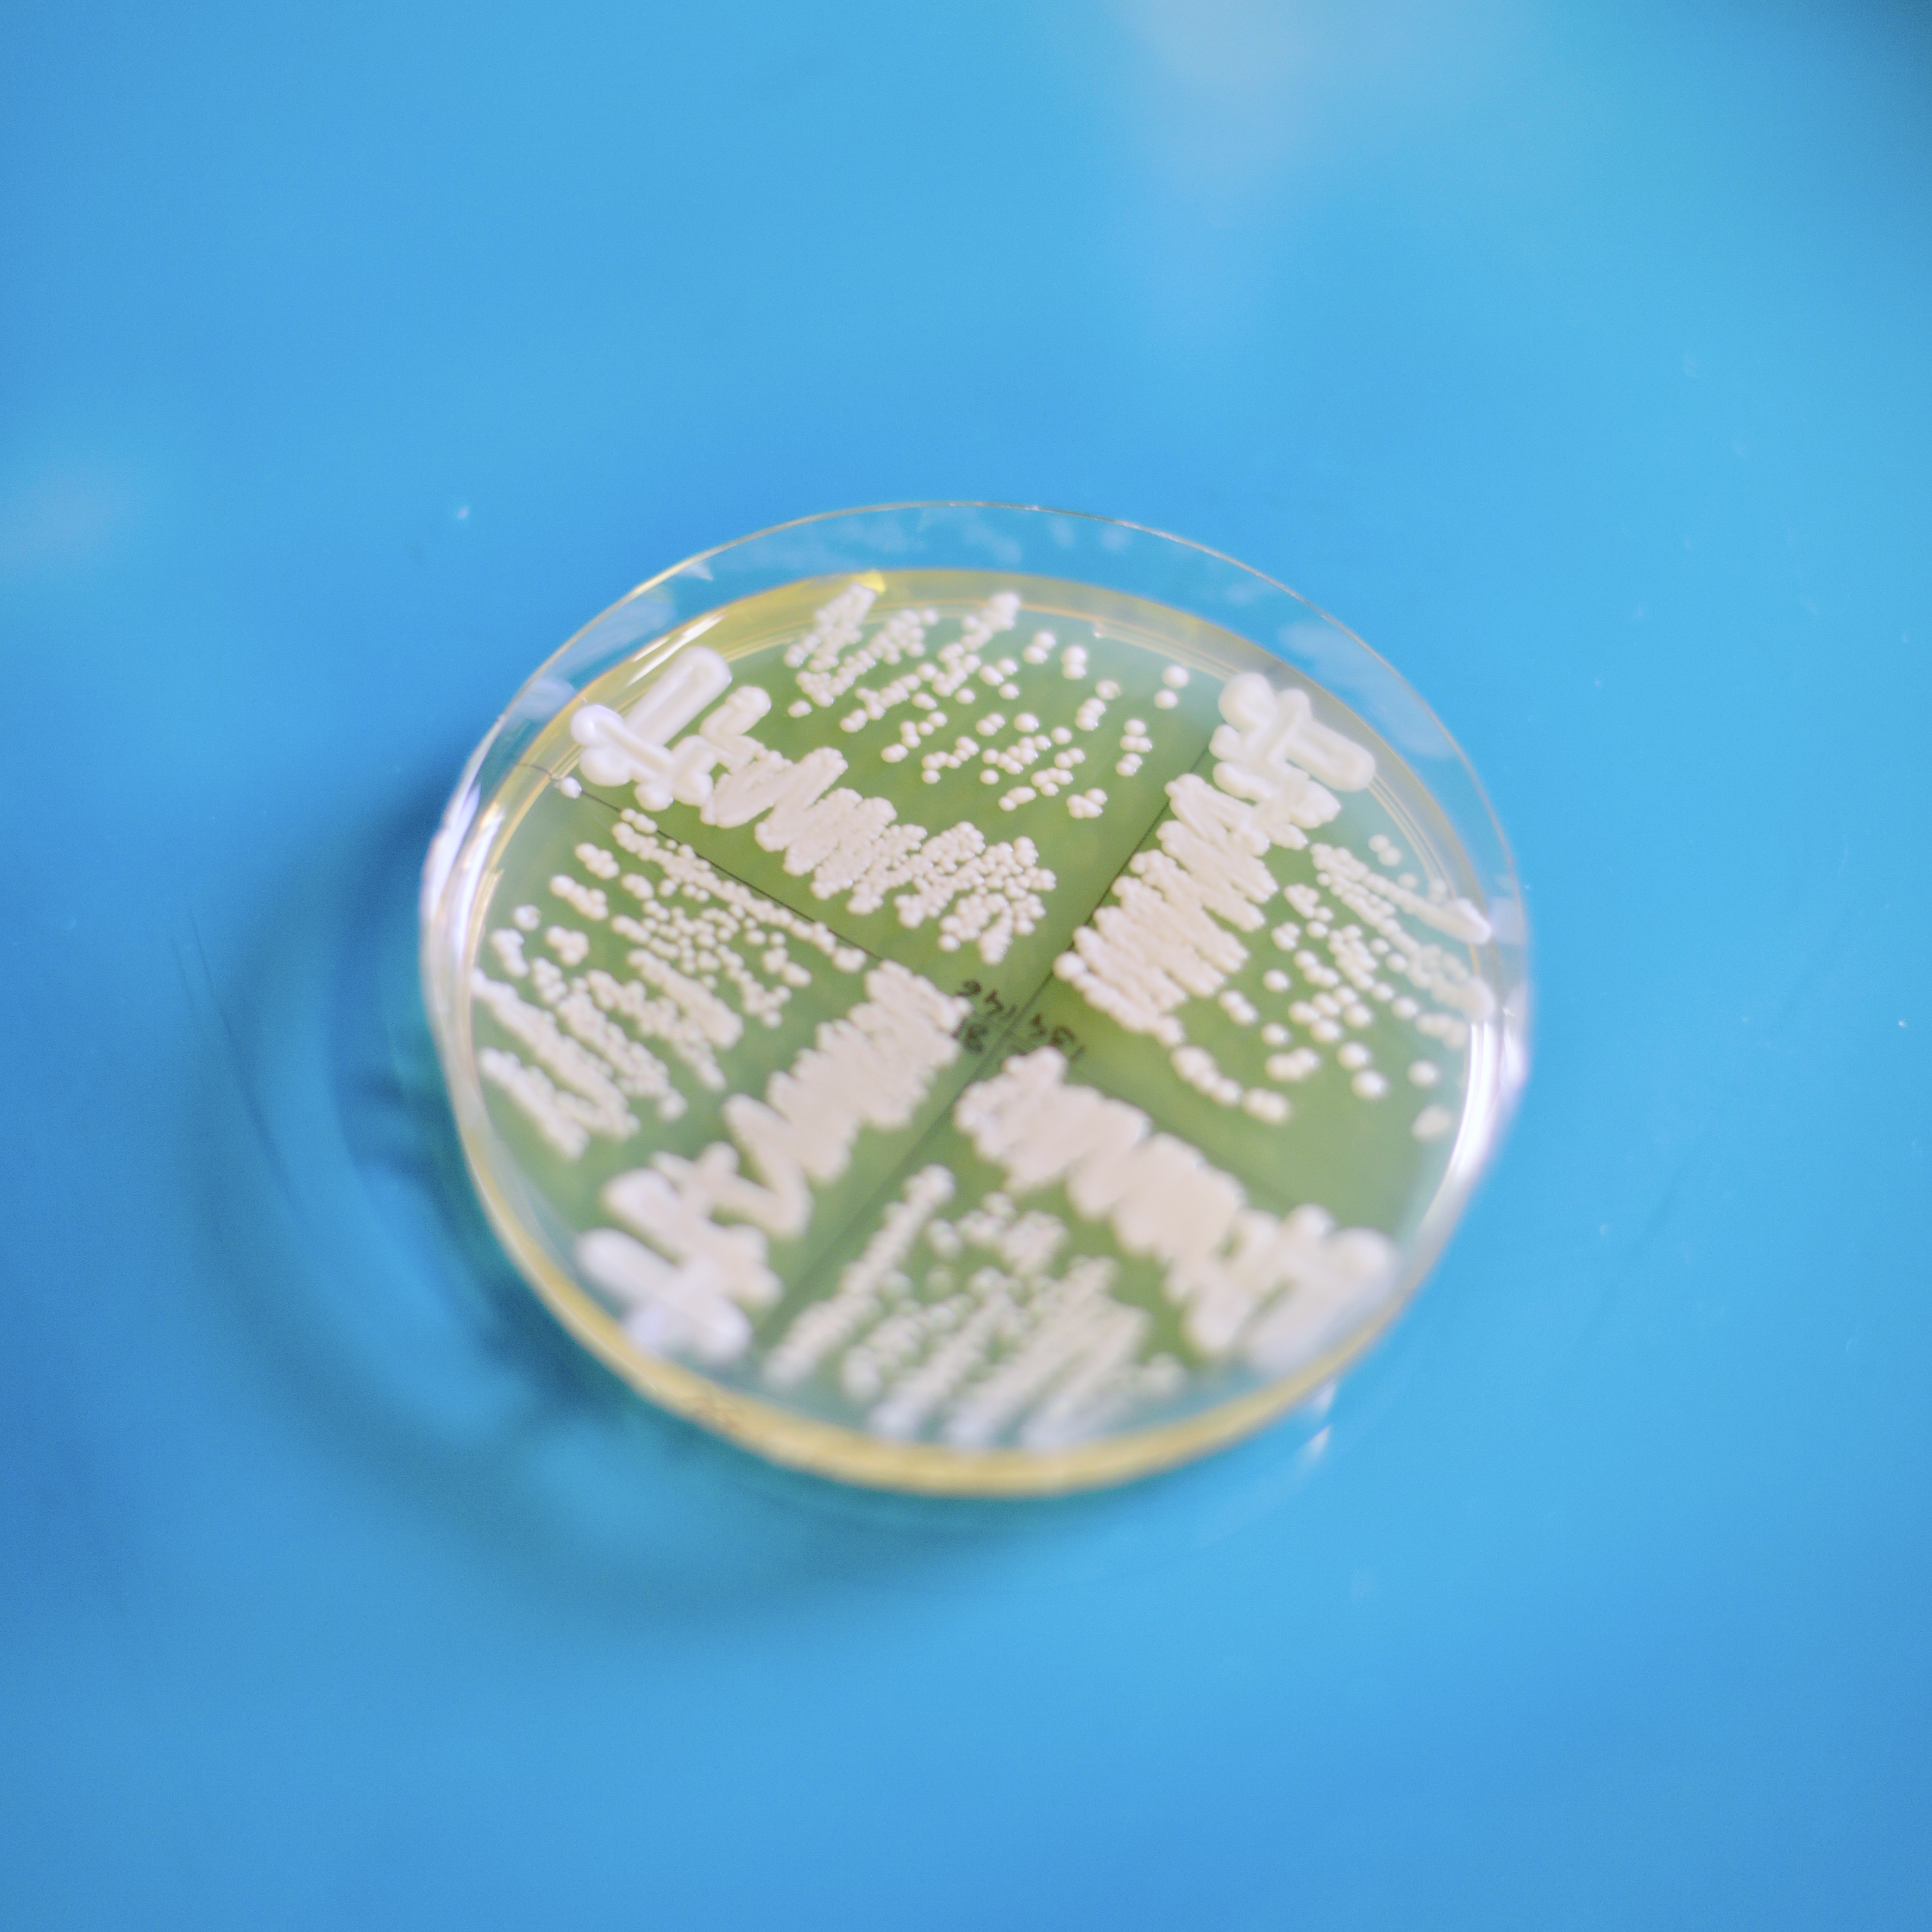

Gianni Liti, chercheur CNRS à l'Institut de Recherche sur le Cancer et le Vieillissement (IRCAN), cherche à comprendre les mécanismes par lesquels le matériel génétique d'un groupe génétiquement défini est incorporé de manière permanente dans un autre groupe, à partir d'un hybride ancestral.

Les coulisses d'une carrière en recherche
Gianni Liti, chercheur CNRS à l'Institut de Recherche sur le Cancer et le Vieillissement (IRCAN), cherche à comprendre les mécanismes par lesquels le matériel génétique d'un groupe génétiquement défini est incorporé de manière permanente dans un autre groupe, à partir d'un hybride ancestral.

En quoi consiste votre recherche ?
« Nos recherches ont des implications pratiques à deux niveaux. La plupart de nos efforts sont consacrés à la recherche fondamentale et ces découvertes contribuent à une meilleure compréhension de la science, ce qui représente un héritage et une ressource pour la société humaine avec un impact à long terme sur de nombreux domaines tels que la médecine, l'agriculture et l'environnement. Nous travaillons sur Saccharomyces cerevisiae, un microbe dont les industries biotechnologiques représentent plusieurs milliards d'euros et nos recherches peuvent avoir des applications industrielles directes. »
Y a-t-il eu un moment particulier dans votre vie où vous avez su que vous vouliez devenir chercheur ?
« Je ne me souviens pas d'un moment précis ; je pense que je devais être jeune puisque parmi les premiers cadeaux de mon enfance, j'ai reçu une boîte de chimie expérimentale et un microscope.
Pendant mon stage de maîtrise d'un an dans un laboratoire en Italie en 1996, j'ai passé de longues journées dans le laboratoire avec de nombreux chercheurs, dont plusieurs revenaient des États-Unis et avaient des histoires fascinantes à raconter. Je me suis dit que j'aimerais bien devenir l'un d'entre eux. »
Qu'est-ce qui vous a initialement attiré vers votre domaine de recherche ?
« Au départ, j'étais curieux des microbes en général, car, bien qu'invisibles à l'œil nu, ils peuvent avoir des effets profonds sur tous les écosystèmes de la planète ainsi que sur les sociétés humaines. Ensuite, j'ai réalisé à quel point les systèmes biologiques sont puissants pour dévoiler les principes de la biologie et comment ils peuvent être utilisés dans des expériences de laboratoire pour comprendre l'évolution. »
Ses inspirations
« J'ai rencontré de nombreux scientifiques de renom qui ont été une source d'inspiration. Lorsque j'ai déménagé en Angleterre, j'ai été surpris de constater à quel point il était facile d'interagir avec eux, que ce soit dans le domaine scientifique ou dans la vie de tous les jours. Parmi eux, j'aimerais citer Edward Louis (mon ancien mentor), Sir Alec Jeffreys (qui a découvert l'empreinte génétique) et Richard Durbin (qui a apporté une contribution déterminante à l'analyse du génome). Parmi les jeunes générations, j'aime beaucoup interagir avec Pedro Beltrao et Markus Ralser. »
La médiation scientifique selon Gianni Liti
Que vous apporte de parler de vos recherches au grand public ?
« Ma principale motivation découle de la curiosité et de l'intérêt que de nombreuses personnes portent à la science.
Il est toujours intéressant de discuter de science avec les gens et de découvrir comment la société perçoit la science et notre travail. »
Partager vos recherches avec les scolaires est-il (ou serait-il) un moyen efficace pour leur donner envie de s'intéresser aux sciences et pourquoi pas s'orienter vers les sciences ?
« La science fascine les jeunes depuis de nombreuses générations et le fait de partager notre travail avec eux est un moyen important d'inciter les élèves à s'intéresser à la science.
De plus, les questions spontanées des écoliers sont à la fois surprenantes et agréables. Il existe de nombreux programmes en France pour assurer ce lien. »
Que diriez-vous à un collègue pour le convaincre de se lancer dans la médiation scientifique ?
« Discuter de science avec le public est à la fois gratifiant et difficile.
Nous n'avons pas l'habitude d'expliquer notre travail avec des mots simples, et c'est un exercice qui profite aux deux parties.
Personnellement, discuter de science avec le public me fait réfléchir d'une manière différente dans un contexte plus large à mon propre travail. »
Auriez-vous une anecdote à partager en lien avec votre expérience en médiation scientifique ?
« Lorsque j'explique que le point culminant de notre travail consiste à rédiger un article scientifique basé sur les expériences que nous avons réalisées, que cet article est examiné par d'autres scientifiques et qu'il sera finalement publié dans une revue, on me demande souvent combien la revue nous paie pour rédiger l'article. Lorsque j'explique que nous payons les frais de publication, je vois bien qu'ils nous prennent pour des fous... (et ils ont probablement raison). »

Pensez-vous que les décideurs politiques pourraient davantage échanger avec les chercheuses et les chercheurs pour prendre certaines décisions ?
« Je crois que c'est déjà le cas dans notre société. »
L'objet de Gianni Liti
Pour sortir des sentiers battus, nous avons demandé à ce chercheur de choisir un objet emblématique de ses études.
Le résultat ? Une boîte de Petri !
« J'ai choisi une boîte de Petri contenant un milieu solide avec des colonies de levure.
Cet objet simple est très puissant et a permis la découverte, l'isolement et l'identification de microbes qui ont eu un effet profond sur les sociétés humaines, comme les bactéries mortelles qui peuvent tuer des millions de personnes et les moisissures qui nous ont fourni des antibiotiques permettant de nous sauver des bactéries.
Les levures ont également interagi pendant au moins 10 000 ans avec les sociétés humaines en nous fournissant de la bière, du pain, du vin, etc. »
Découvrez le projet GONG !
